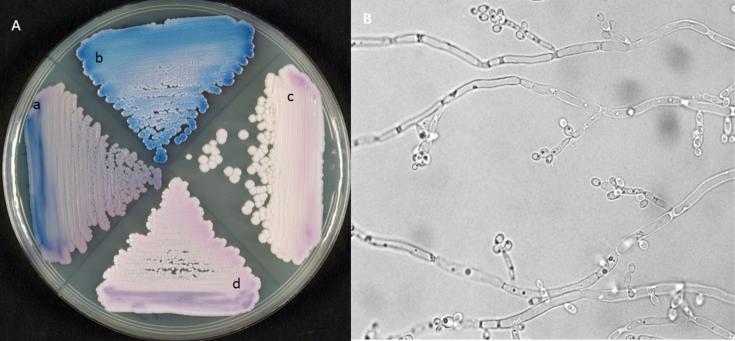
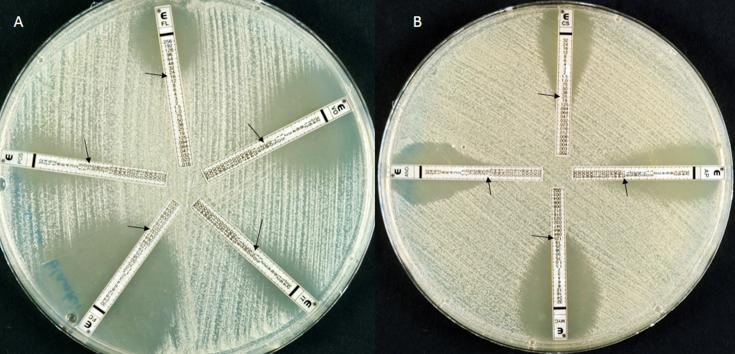

唑类耐药作为血流感染新发现的病因。
Azole-resistant as a newly recognized cause of bloodstream infection.
作者信息
Al-Haqqan A, Al-Sweih N, Ahmad S, Khan S, Joseph L, Varghese S, Khan Z
机构信息
Microbiology Department, Maternity Hospital, Shuwaikh, Kuwait.
Department of Microbiology, Faculty of Medicine, Kuwait University, Safat, Kuwait.
出版信息
New Microbes New Infect. 2018 Jun 23;26:25-29. doi: 10.1016/j.nmni.2018.06.008. eCollection 2018 Nov.
is a newly recognized human pathogen. Here we describe a case of bloodstream infection in a preterm neonate. The yeast was repeatedly isolated from blood, and its identity was confirmed by PCR sequencing of rDNA. Additionally, DNA was detected directly in a blood sample. The isolates initially developed pink colonies on CHROMagar Candida which later turned into dark metallic blue similar to . Inaccurate identification by the VITEK 2 yeast identification system as and intrinsic resistance to fluconazole (MIC 12-16 μg/mL) underscore the need for its accurate identification for appropriate therapeutic management.
是一种新发现的人类病原体。在此我们描述一例早产儿血流感染病例。该酵母菌多次从血液中分离出来,其身份通过rDNA的PCR测序得以确认。此外,在一份血液样本中直接检测到了DNA。分离株最初在科玛嘉念珠菌显色培养基上形成粉红色菌落,后来变成类似于……的暗金属蓝色。VITEK 2酵母菌鉴定系统将其错误鉴定为……以及对氟康唑的固有耐药性(MIC为12 - 16μg/mL)强调了准确鉴定它以进行适当治疗管理的必要性。